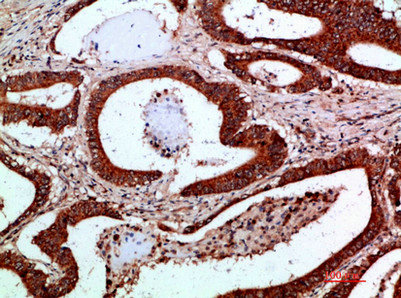

IKBKG Antibody
-
中文名稱:IKBKG兔多克隆抗體
-
貨號:CSB-PA899361
-
規格:¥1090
-
圖片:
-
Western blot analysis of mouse-kidney mouse-brain mouse-lung mouse-heart 293T lysate, antibody was diluted at 1000. Secondary antibody was diluted at 1:20000
-
Immunohistochemical analysis of paraffin-embedded human-colon-cancer, antibody was diluted at 1:200
-
Immunohistochemical analysis of paraffin-embedded human-colon-cancer, antibody was diluted at 1:200
-
Immunohistochemical analysis of paraffin-embedded human-brain, antibody was diluted at 1:200
-
Immunohistochemical analysis of paraffin-embedded human-brain, antibody was diluted at 1:200
-
-
其他:
產品詳情
-
Uniprot No.:
-
基因名:
-
別名:IkB kinase associated protein 1 antibody; IkB kinase subunit gamma antibody; Inhibitor of nuclear factor kappa B kinase subunit gamma antibody; AMCBX1 antibody; FIP 3 antibody; FIP-3 antibody; FIP3 antibody; Fip3p antibody; I kappa B kinase gamma antibody; I-kappa-B kinase subunit gamma antibody; IkB kinase gamma subunit antibody; IkB kinase subunit gamma antibody; IkB kinase-associated protein 1 antibody; Ikbkg antibody; IKK gamma antibody; IKK-gamma antibody; IKKAP1 antibody; IKKG antibody; IMD33 antibody; Incontinentia pigmenti antibody; Inhibitor of kappa light polypeptide gene enhancer in B cells, kinase gamma antibody; Inhibitor of kappa light polypeptide gene enhancer in B cells, kinase of, gamma antibody; Inhibitor of nuclear factor kappa-B kinase subunit gamma antibody; IP antibody; IP1 antibody; IP2 antibody; IPD2 antibody; NEMO antibody; NEMO_HUMAN antibody; NF kappa B essential modifier antibody; NF kappa B essential modulator antibody; NF-kappa-B essential modifier antibody; NF-kappa-B essential modulator antibody; ZC2HC9 antibody
-
宿主:Rabbit
-
反應種屬:Human,Mouse,Rat
-
免疫原:Synthetic peptide from Human protein at AA range: 60-120
-
免疫原種屬:Homo sapiens (Human)
-
標記方式:Non-conjugated
-
純化方式:The antibody was affinity-purified from rabbit serum by affinity-chromatography using specific immunogen.
-
濃度:It differs from different batches. Please contact us to confirm it.
-
保存緩沖液:Liquid in PBS containing 50% glycerol, 0.5% BSA and 0.02% sodium azide.
-
產品提供形式:Liquid
-
應用范圍:WB, IHC, ELISA
-
推薦稀釋比:
Application Recommended Dilution WB 1:500-2000 IHC 1:50-300 ELISA 1:10000-20000 -
Protocols:
-
儲存條件:Upon receipt, store at -20°C or -80°C. Avoid repeated freeze.
-
貨期:Basically, we can dispatch the products out in 1-3 working days after receiving your orders. Delivery time maybe differs from different purchasing way or location, please kindly consult your local distributors for specific delivery time.
-
用途:For Research Use Only. Not for use in diagnostic or therapeutic procedures.
相關產品
靶點詳情
-
功能:Regulatory subunit of the IKK core complex which phosphorylates inhibitors of NF-kappa-B thus leading to the dissociation of the inhibitor/NF-kappa-B complex and ultimately the degradation of the inhibitor. Its binding to scaffolding polyubiquitin plays a key role in IKK activation by multiple signaling receptor pathways. Can recognize and bind both 'Lys-63'-linked and linear polyubiquitin upon cell stimulation, with a much higher affinity for linear polyubiquitin. Could be implicated in NF-kappa-B-mediated protection from cytokine toxicity. Essential for viral activation of IRF3. Involved in TLR3- and IFIH1-mediated antiviral innate response; this function requires 'Lys-27'-linked polyubiquitination.; (Microbial infection) Also considered to be a mediator for HTLV-1 Tax oncoprotein activation of NF-kappa-B.
-
基因功能參考文獻:
- Computational analysis identified two miR-107 binding sites in the 3'UTR of IKBKG suggesting that IKBKG expression is regulated by miR-107. PMID: 30396951
- Human IKKgamma does not interact with mammalian Atg8-family proteins. PMID: 29097655
- Data suggest the angiopoietin-like 8 (ANGPTL8)/p62-IKKgamma axis as a negative feedback loop that regulates NF-kappaB activation, and extends the role of selective autophagy in fine-tuned inflammatory responses. PMID: 29255244
- this study demonstrates immunodeficiency in two female patients with Incontinentia Pigmenti with heterozygous NEMO mutation diagnosed by lipopolysaccharide unresponsiveness PMID: 28702714
- GSK-3beta is critically important for ordered NF-kappaB signalling through modulation of NEMO phosphorylation. PMID: 27929056
- HOTAIR operates the action of IKKalpha, IKKbeta, IKKgamma in liver cancer stem cells PMID: 27367027
- the present study found that loss of the NEMO-SHARPIN interaction impaired recruitment of truncated NEMO forms into punctuate structures that are transiently formed on cell stimulation and thus led to a defect in linear ubiquitination PMID: 28249776
- NEMO was critically involved in the cGAS-STING pathway. PMID: 28939760
- Results show that NEMO's expression is regulated by ASAP3 which it interacts directly with it reducing its poly-ubiquitinylation. PMID: 28502111
- E+P treatment of breast cancer cells increased ER binding to the NEMO promoter, thereby increasing NEMO expression. PMID: 28515148
- Hematopoietic stem cell transplantation can cure most clinical features of patients with a variety of IKBKG mutations. PMID: 28679735
- Authors show that NEMO stabilizes HIFalpha via direct interaction and independently of NF-kappaB signaling in vitro. NEMO prolongs tumor cell survival via regulation of apoptosis and activation of epithelial-to-mesenchymal transition, facilitating tumor metastasis. PMID: 26500060
- The results demonstrate the the first example of father-to-daughter transmission of IP in which a pathogenic mutation in IKBKG has been demonstrated PMID: 27037530
- Molluscum contagiosum virus MC005 inhibited NF-kappaB proximal to the IkappaB kinase (IKK) complex, and unbiased affinity purification revealed that MC005 interacts with the IKK subunit NEMO (NF-kappaB essential modulator). PMID: 28490597
- These data suggest that molluscum contagiosum virus MC159 competitively binds to NEMO to prevent cIAP1-induced NEMO polyubiquitination. PMID: 28515292
- High IKBKG expression is associated with multiple myeloma. PMID: 27454822
- Our findings shed light on the nature of the interaction between NEMO and poly-ubiquitin, suggesting that NEMO is differentially regulated by poly-ubiquitin chain length and that this regulation occurs via a modulation of the available equilibrium of conformational states, rather than gross structural change PMID: 27028374
- FADD, as well as NEMO, is a substrate for LUBAC ubiquitin ligase (E3) complex, composed of the HOIP, HOIL-1L, and SHARPIN subunits. PMID: 28189684
- Consistent with experimental evidence, the zinc ion is essential for mechanical stabilization of the functional, folded conformation of NEMO. PMID: 28035815
- Herein, our simulations of the zinc finger NEMO (2JVX) using multiple simulations of length 15, 30, 1000, and 3000 ns are analyzed to provide clarity on this point. PMID: 25734227
- Deletion of exons 4 to 10 (NEMODelta4-10) accounts for about 80% of cases (familial and sporadic) of Incontinentia pigmenti. PMID: 26564087
- results further reveal that cFLIPLrequires the linear ubiquitin chain assembly complex and the kinase TAK1 for activation of the IKK kinase PMID: 26865630
- USP18 negatively regulates NF-kappaB signaling by targeting TAK1 and NEMO for deubiquitination through distinct mechanisms. PMID: 26240016
- A missense mutation in IKBKG causes a Nager syndrome or an atypical incontinentia pigmenti phenotype. IKBKG mutations are typically associated with preterm male death, but this variant is associated with survival for 8-15 days. PMID: 25441681
- Recruitment of A20 to the C-terminal domain of NEMO represents a novel mechanism limiting NF-kappaB activation by NEMO, and its absence results in autoinflammatory disease. PMID: 26802121
- Authors show that Rab11-GMPPNP-FIP3-Rabin8 is more stable than Rab11-GMPPNP-Rabin8, owing to direct interaction between Rabin8 and FIP3 within the dual effector-bound complex. PMID: 26258637
- Somatic mosaicism of a novel IKBKG nonsense mutation in a male patient with incontinentia pigmenti. PMID: 25944529
- COMMD7's binding to NEMO does not interfere with the binding to the IKKs, and that the disruption of the IKK complex through the use of the NBP competitor impairs the termination of NF-kappaB activity PMID: 26060140
- findings suggest that rare, functional variants in MYD88, IRAK4 or IKBKG do not significantly contribute to IPD susceptibility in adults at the population level PMID: 25886387
- the incontinentia pigmenti patients presented a common IKBKG exon 4-10 deletion PMID: 24073555
- A novel mutation, designated c.916G>A (p.D306N) is described. NEMO expression was unaffected, but ubiquitylation was decreased causing ectodermal dysplasia, immunodeficiency, incontinentia pigmenti, and immune thrombocytopenic purpura. PMID: 26117626
- IKKgamma is a parallel coiled-coil whose response to binding of vFLIP or IKKbeta is localized twisting. PMID: 25979343
- IPO3 binds NEMO, promotes its nuclear import, and is critical for DNA damage-dependent NF-kappaB activation. PMID: 26060253
- unanchored polyubiquitin has a role in regulation by inducing NEMO conformational change by an allosteric mechanism PMID: 25866210
- The stability of the NEMO coiled coil is maintained by strong interhelix interactions in the region centered on residue 54. PMID: 25400026
- Mass spectrometric analysis demonstrated that WA covalently modifies NEMO on a cysteine residue within the C-terminal zinc finger (ZF) domain. Point mutations to the ZF can reverse the WA-induced Lys-48-polyubiquitin binding phenotype PMID: 25296760
- NEMO patients without ectodermal dysplasia and anhidrosis have more robust immunologic responses. PMID: 24682681
- the rescuing of the binding affinity implies that a preordered IKK-binding region of NEMO is compatible with IKK binding, and the conformational heterogeneity observed in NEMO(44-111) may be an artifact of the truncation. PMID: 25286246
- IKBKG gene mutation was discovered as a cause for incontinentia pigmenti. (Meta-analysis) PMID: 23802866
- We report the results of genomic analysis for a girl with incontinentia pigmenti, but without NEMO mutation PMID: 24487970
- Data suggest the potential of targeting of Nemo-Like Kinase (NLK) to treat a range of tumourigenic conditions characterised by PTEN deficiency. PMID: 23144700
- 21 new point mutations have been reported, which further extend the spectrum of pathologic variants in Incontinentia pigmenti patients: premature stop codon, frameshift mutation, or a partial loss of NEMO/IKKgamma activity (splicing and missense). PMID: 24339369
- p62 interacts with NEMO, the regulatory subunit of the complex responsible for activation of NF-kappaB transcription factor. PMID: 24270048
- NEMO is essential for Kaposi's sarcoma-associated herpesvirus-encoded vFLIP K13-induced gene expression and protection against death receptor-induced cell death. PMID: 24672029
- Identified is a post-translational modification of NEMO - phosphorylation of residue 387. Phosphorylation of serine 387 is not an absolute requirement for NF-kappaB signalling. PMID: 24012789
- IKKgamma facilitates RhoA activation via a guanine nucletotide exchange factor, which in turn activates ROCK to phosphorylate IKKbeta, leading to NF-kappaB activation that induced the chemokine expression and cell migration upon TGF-beta1. PMID: 24240172
- Data suggest that all seven cysteines (4 in zinc finger domain) of NEMO (NF-kappaB essential modulator protein) can be simultaneously mutated to alanine without affecting binding affinity of NEMO for I-kappa B kinase beta catalytic subunit. PMID: 24266532
- USP10 inhibits genotoxic NF-kappaB activation by MCPIP1-facilitated deubiquitination of NEMO. PMID: 24270572
- Merkel cell polyomavirus small T antigen targets the NEMO adaptor protein to disrupt inflammatory signaling. PMID: 24109239
- NEMO ZF, like other NEMO related-ZFs, binds mono-Ub and di-Ub with distinct stoichiometries, indicating the presence of a new Ub site within the NEMO ZF. PMID: 24100029
顯示更多
收起更多
-
相關疾病:Ectodermal dysplasia, anhidrotic, with immunodeficiency X-linked (EDAID); Ectodermal dysplasia, anhidrotic, with immunodeficiency, osteopetrosis and lymphedema (OLEDAID); Immunodeficiency, NEMO-related, without anhidrotic ectodermal dysplasia (NEMOID); Immunodeficiency 33 (IMD33); Recurrent isolated invasive pneumococcal disease 2 (IPD2); Incontinentia pigmenti (IP)
-
亞細胞定位:Cytoplasm. Nucleus.
-
組織特異性:Heart, brain, placenta, lung, liver, skeletal muscle, kidney and pancreas.
-
數據庫鏈接:
Most popular with customers
-
-
YWHAB Recombinant Monoclonal Antibody
Applications: ELISA, WB, IHC, IF, FC
Species Reactivity: Human, Mouse, Rat
-
Phospho-YAP1 (S127) Recombinant Monoclonal Antibody
Applications: ELISA, WB, IHC
Species Reactivity: Human
-
-
-
-
-